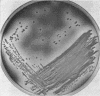
992

Abstract
Incorporation of methyl green dye into an agar medium containing deoxyribo-nucleic acid results in an improved medium for detecting deoxyribonuclease-producing bacteria. Use of the dye makes it unnecessary to use acid to demonstrate deoxyribonuclease activity, thus allowing subculture or reincubation of colonies. The improved medium is highly sensitive and can be used for primary isolation of Staphylococcus aureus or group A Streptococcus pyogenes.
Full text
PDF


Images in this article
Selected References
These references are in PubMed. This may not be the complete list of references from this article.
- Blair E. B., Emerson J. S., Tull A. H. A new medium, salt mannitol plasma agar, for the isolation of Staphylococcus aureus. Am J Clin Pathol. 1967 Jan;47(1):30–39. doi: 10.1093/ajcp/47.1.30. [DOI] [PubMed] [Google Scholar]
- JEFFRIES C. D., HOLTMAN D. F., GUSE D. G. Rapid method for determining the activity of microorganisms on nucleic acids. J Bacteriol. 1957 Apr;73(4):590–591. doi: 10.1128/jb.73.4.590-591.1957. [DOI] [PMC free article] [PubMed] [Google Scholar]
- KURNICK N. B. The determination of desoxyribonuclease activity by methyl green; application to serum. Arch Biochem. 1950 Nov;29(1):41–53. [PubMed] [Google Scholar]
- Lachica R. V., Deibel R. H. Detection of nuclease activity in semisolid and broth cultures. Appl Microbiol. 1969 Aug;18(2):174–176. doi: 10.1128/am.18.2.174-176.1969. [DOI] [PMC free article] [PubMed] [Google Scholar]
- Nelson J., Ayoub E. M., Wannamaker L. W. Streptococcal anti-desoxyribonuclease B: microtechnique determination. J Lab Clin Med. 1968 May;71(5):867–873. [PubMed] [Google Scholar]
- Schreier J. B. Modification of deoxyribonuclease test medium for rapid identification of Serratia marcescens. Am J Clin Pathol. 1969 Jun;51(6):711–716. doi: 10.1093/ajcp/51.6.711. [DOI] [PubMed] [Google Scholar]
- Valu J. A. Use of the deoxyribonuclease test as an aid in the differentiation of Paracolobactrum (Hafnia) from serratia. J Bacteriol. 1966 Jan;91(1):467–468. doi: 10.1128/jb.91.1.467-468.1966. [DOI] [PMC free article] [PubMed] [Google Scholar]